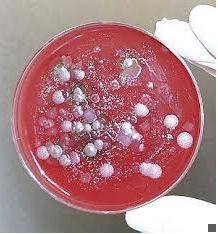
Bioterrorismo

Considerada a mais temidas das armas, abiológica tem efeitos devastadores e desconhecidos pela maioria dos médicos.
São vírus e bactérias transformados geneticamente em laboratórios para se tornarem resistentes aos tratamentos. Podem matar ou incapacitar um inimigo, ou animais e plantas de uma nação adversária.
O uso de armas biológicas, feitas com vírus e bactérias, é impossível de ser detectado por equipamentos de segurança. Armas que podemdizimar populações ao contaminar o ar, a água ou os alimentos e para as quais não há tratamento.
Uma forma de guerra biológica já era praticada na Antiguidade, quando os exércitos usavam cadáveres putrefatos para contaminar o abastecimento de água de uma cidade sitiada, ou atiravam dentro das muralhas inimigas cadáveres de vítimas de varíola.

Atualmente entre essas armas estão bactérias (ou as toxinas que produzem), vírus e fungos. Laboratórios de guerra bacteriológica foram criados pelas superpotências, EUA e a ex-URSS, durante a Guerra Fria. O único uso documentado de armas biológicas em combate foi pelos japoneses contra cidades chinesas no final da década de 30 e início da década de 40. Também foram atribuídos aos japoneses experimentos com agentes bacteriológicos em "cobaias" humanas (principalmente prisioneiros de guerra).
Esses microorganismos são transformados em armas letais em laboratórios de vários países. Na lista de produtores de armas biológicas estão Iraque, Irã, Síria, Líbia, Índia, Paquistão e China. Além disso, o serviço de inteligência americano informou que países como Estados Unidos, Rússia, Irã, Iraque, Líbia, Coréia do Norte e Afeganistão mantêm esses laboratórios, onde cultivam as chamadas armas de destruição de massa.
Documento da Organização Mundial da Saúde, divulgado recentemente, alerta ser real a ameaça do uso de armas biológicas. Os especialistas da OMS constatam que "avanços em tecnologia tornaram possível aos terroristas matarem milhões de pessoas com armas biológicas e químicas". Eles relatam, em 179 páginas, todos os conhecimentos disponíveis sobre o bioterrorismo. A OMS recebeu vários telefonemas de governos solicitando conselhos de como combater uma possível guerra biológica.
Anthrax, botulismo, varíola e vírus Ebola integram o arsenal do terrorismo biológico. Como o antraz, o botulismo e diversas pestes estão presentes na maioria dos continentes, suas toxinas são facilmente obtidas. Baratos de produzir e simples de transportar podem atingir com pequena quantidade área muito grande.
 A varíola é adquirida através de um vírus, transmitido pelo ar, por isso a contaminação ocorre através da respiração.
A varíola é adquirida através de um vírus, transmitido pelo ar, por isso a contaminação ocorre através da respiração.
Essa doença, como as outras usadas como armas, apresenta sintomas semelhantes aos da gripe. A erupção de pústulas na pele é uma das características da doença.
Os últimos casos confirmados de varíola foram diagnosticados há mais de duas décadas. existem, no mundo, dois laboratórios conhecidos com estoque de vírus vivo: um nos estados unidos e o outro na Rússia. após exposição respiratória e um período de incubação de 12 dias, a varíola evolui, em pacientes não vacinados, com taxas de mortalidade em torno de 30%.
Dois antivirais disponíveis comercialmente têm atividade contra o vírus da varíola: o cidofovir e a ribavirina. não se dispõe, atualmente, de vacina comercialmente disponível; o centers for disease control (cdc) tem uma reserva de alguns milhões de doses da vacina para prevenir uma nova emergência da doença e outro tanto de imunoglobulina para tratar os potenciais complicações da vacina.
 O Ebola é um dos agentes de guerra biológica mais temíveis. A mortalidade atinge quase 100%. Após a contaminação, a pessoa passa a sentir, em uma semana, febre, muita dor de cabeça, falta de ar, a ter diarréia com sangue e expectoração também hemorrágica. A vítima morre, no máximo, em duas semanas. Não há tratamento para essa doença contagiosa, transmitida de pessoa a pessoa pela respiração, catarro, secreção ou , gotículas de tosse. Para uma pessoa ser contaminada bastam apenas 10 vírus. A disseminação pode ser por aerossol ou ,ainda, por alimento ou água contaminados pelo vírus. Classificado como um vírus de fácil cultivo e armazenamento , o Ebola pode ficar vários anos em um tubo de ensaio até ser espalhado na população. O Ebola é uma arma letal.
O Ebola é um dos agentes de guerra biológica mais temíveis. A mortalidade atinge quase 100%. Após a contaminação, a pessoa passa a sentir, em uma semana, febre, muita dor de cabeça, falta de ar, a ter diarréia com sangue e expectoração também hemorrágica. A vítima morre, no máximo, em duas semanas. Não há tratamento para essa doença contagiosa, transmitida de pessoa a pessoa pela respiração, catarro, secreção ou , gotículas de tosse. Para uma pessoa ser contaminada bastam apenas 10 vírus. A disseminação pode ser por aerossol ou ,ainda, por alimento ou água contaminados pelo vírus. Classificado como um vírus de fácil cultivo e armazenamento , o Ebola pode ficar vários anos em um tubo de ensaio até ser espalhado na população. O Ebola é uma arma letal.
A peste bubônica pode ser disseminada por aerossóis, mísseis, bombas ou através de pulga infectada. 50 quilos de esporos dessa bactéria podem contaminar uma cidade de 5 milhões de habitantes. Uma vez infectada, a pessoa vai contagiar todas as outras com que tiver contato.
Os sintomas aparecem em três dias. A doença atinge o ápice em uma semana, período em que a pessoa pode morrer. Começa com um quadro parecido com gripe, depois aparecem pústulas e gânglios generalizado no corpo e úlcera na pele. É altamente contagiosa.
O tratamento é com antibióticos. E conta que é justamente nas regiões do Oriente Médio, África e sudeste asiático que a bactéria causadora da peste bubônica é cultivada com extrema facilidade. Então, com certeza, são muitos os países que têm esse agente infeccioso, que pode, ainda ser disseminado por animais domésticos, como o cão, o gato, gado e porcos.
Se forem espalhados por aeronave ao longo de dois quilômetros podem se estender, com a ajuda do vento, por 20 quilômetros, enquanto está sendo espalhado não pode ser detectado porque é incolor e sem cheiro.As pesquisas da universidade americana relatam que documentos de 1995 indicam que o Iraque produziu até 8 mil litros de anthrax para serem lançados por mísseis Scud. Mesmo com a pressão internacional, a produção de armas biológicas do Iraque continua intacta.
O anthrax pode lesar a pele, contaminar os pulmões ou causar doenças gastrintestinais. Começa como se fosse uma gripe. A pessoa passa a sentir dor no corpo, a expelir catarro. Depois, passa a ter manchas e pequenas vesículas na pele. Evolui, em seguida para hemorragia, edema e falência dos órgãos. A pessoa pode morrer em cinco dias. A bactéria anthrax pode, ainda, causar meningite, que significa morte.
Para se prevenir é necessário cobrir todo o corpo com roupas com duas camadas e equipamento de proteção respiratória. Para as roupas pode ser qualquer tecido. O importante é que proteja todo o corpo, porque o bacilo não penetra nos poros do tecido.
Tratar o anthrax significa usar antibióticos, "penicilina e tetraciclina". O contágio de pessoa para pessoa não é conhecido.
Ela provoca sintomas de paralisia progressiva, principalmente paralisia dos músculos da respiração, levando á falta de ar. Não tem tratamento. A mortalidade é alta.
Numa guerra biológica, é espalhada sobre reservatórios de água ou estoques de alimentos. Com spray, pode contaminar alimentos prontos. O consumo dessa água ou desses alimentos leva à imediata intoxicação. Depois de contaminados, não há como purificar essa água ou esses alimentos. Nem com o calor, caso os alimentos sejam cozidos ou assados. A evolução da doença acontece de 12 a 36 horas após a ingestão desses produtos. A morte pode ocorrer em 48 horas.
Essa toxina deriva de fungos e é cultivada em vários alimentos como o milho e o trigo. É capaz de destruir tecidos, principalmente os que apresentam multiplicação como a medula óssea, por exemplo. Podem causar destruição também no sistema gastrintestinal, no testículo e vários outros sistemas.
Os sintomas da contaminação pela toxina t-2 são imediatos. Ocorrem em poucos minutos, após a exposição, e podem durar até dez dias. Para produzi-la não é necessária tecnologia complicada, são apenas técnicas de extração e purificação. Ela ocorre com certa facilidade em ambientes de estocagem de grãos. É, portanto, um veneno fácil de produzir. Como não é destruída pelo calor, pode ficar estocada por muito tempo. Não se sabe quais países estariam usando, mas é de se imaginar que todos os que eventualmente estão pensando em armas biológicas, devem ter estoques destas substâncias tóxicas e de outras também. Só esperam pela oportunidade de disseminá-las. Ela pode ser espalhada por aerossóis. À medida em que vai descendo, vai atingindo as pessoas na pele, pela respiração ou pelos alimentos.
A toxina t-2 é mais uma arma biológica que não pode ser detectada por nenhum sistema de segurança por não ter nem cor nem cheiro, seus sintomas também são como os da gripe.
 Os americanos buscam auxílio lotando consultórios de psicólogos e esgotando estoques de máscaras e antibióticos para se proteger de um inimigo invisível: o bioterrorismo. O que o país mais desenvolvido sabe sobre o tratamento das doenças causadas por esses vírus ou bactérias? A resposta surpreende: muito pouco, admitem os cientistas americanos. Hoje, nomes como anthrax, botulismo, toxina t-2 ou varíola causam pânico entre os americanos. E comemoração entre os terroristas. É a grande arma do terrorismo. A mais temida no mundo, definem médicos e cientistas das principais universidades americanas.
Os americanos buscam auxílio lotando consultórios de psicólogos e esgotando estoques de máscaras e antibióticos para se proteger de um inimigo invisível: o bioterrorismo. O que o país mais desenvolvido sabe sobre o tratamento das doenças causadas por esses vírus ou bactérias? A resposta surpreende: muito pouco, admitem os cientistas americanos. Hoje, nomes como anthrax, botulismo, toxina t-2 ou varíola causam pânico entre os americanos. E comemoração entre os terroristas. É a grande arma do terrorismo. A mais temida no mundo, definem médicos e cientistas das principais universidades americanas.
O alerta sobre o uso de armas biológicas foi feito durante reunião dos países da OTAN - Organização do Tratado do Atlântico Norte, em Bruxelas: "Temos de começar a pensar o impensável", declarou o secretário geral da OTAN, George Robertson, sobre o uso de armas biológicas por terroristas.
Uma arma invisível, sem cheiro e que provoca sintomas desconhecidos pela maioria dos médicos é a grande preocupação do governo norte-americano tanto nos ataques terroristas aos EUA como durante uma guerra no Afeganistão. É a arma biológica, que o Centro para Estudos de Biodefesa Civil da Universidade Johns Hopkins, nos Estados Unidos, define como a mais temida numa guerra. Estudos da Universidade Johns Hopkins mostram que os Estados Unidos "não estão preparados para enfrentar um ataque de arma biológica".
Todas as armas biológicas têm uma mesma característica. O maior medo é que os sintomas iniciais são bem semelhantes à gripe, com irritação da garganta, tosse e catarro, depois é que aparecem as lesões fatais. A maioria não tem tratamento. O Centro de Controle de Doenças dos Estados Unidos enviou um comunicado a todos os laboratórios americanos para avisarem em casos de surtos de gripe.
Exemplos da quantidade de vírus ou bactérias necessários para infectar uma população: dois quilos de anthrax, varíola ou t-2 podem contaminar uma população de 150 mil a 300 mil pessoas. Se forem 5 milhões pessoas, são suficientes pouco mais de 30 quilos do vírus da varíola.
O medo da utilização de armas biológicas causou mais prejuízos aos EUA. O governo proibiu todos os vôos de aviões utilizados para pulverizar plantações. A causa foi o medo de terroristas usarem essas aeronaves para espalhar vírus ou bactérias letais em várias regiões americanas.
O uso de vírus e bactérias para infectar soldados ou dizimar populações vem se tornando o pesadelo dos americanos. O risco do bioterrorismo vem sendo alertado pela Organização Mundial da Saúde, após os atentados a Nova York e a Washington. O Centro de Controle de Doenças dos Estados Unidos mandou uma determinação a todos os laboratórios para a comunicação imediata de sintomas das doenças que podem ser causadas por essas armas biológicas. É o bioterrorismo, uma técnica que espalha doenças ainda desconhecidas pela maioria dos médicos, ao transformar geneticamente vírus e bactérias em agentes resistentes a qualquer tratamento.
O método é antigo, mas continua um enigma para quem desenvolve diagnósticos e tratamentos.
São vários os vírus e as bactérias que podem ser desenvolvidas em laboratório para serem, depois, espalhadas por aviões ou lançadas por mísseis durante ataques terroristas ou durante uma guerra. Num simples tubo de ensaio cabem milhões desses micróbios, que podem, por exemplo, serem jogados num sistema de ventilação de um prédio, contaminando todos os moradores.
Realmente as armas biológicas representam um perigo real e assustador, capaz de exterminar um grande número de pessoas, elas vêm aterrorizando o mundo.
Considerando-se a rapidez com que se adquire tecnologia de ponta em todas as áreas da ciência, é perfeitamente possível imaginar que um laboratório, trabalhando com estes (ou outros) microrganismos, possa primeiramente torná-los disponíveis em quantidades capazes de afetar o mundo inteiro e em seguida transformá-los (por manipulações genéticas) em agentes resistentes a todos os mecanismos de defesa atualmente existentes, tais como antimicrobianos, antivirais, vacinas, imunoglobulinas e outros mais.
Só nos resta então a dúvida: o homem é capaz de criar em laboratório microorganismos causadores de doenças fatais, mas não é capaz de encontrar a cura desses males?...Será que ele não será vítima de suas próprias invenções?...
São vírus e bactérias transformados geneticamente em laboratórios para se tornarem resistentes aos tratamentos. Podem matar ou incapacitar um inimigo, ou animais e plantas de uma nação adversária.
O uso de armas biológicas, feitas com vírus e bactérias, é impossível de ser detectado por equipamentos de segurança. Armas que podemdizimar populações ao contaminar o ar, a água ou os alimentos e para as quais não há tratamento.
Uma forma de guerra biológica já era praticada na Antiguidade, quando os exércitos usavam cadáveres putrefatos para contaminar o abastecimento de água de uma cidade sitiada, ou atiravam dentro das muralhas inimigas cadáveres de vítimas de varíola.

Atualmente entre essas armas estão bactérias (ou as toxinas que produzem), vírus e fungos. Laboratórios de guerra bacteriológica foram criados pelas superpotências, EUA e a ex-URSS, durante a Guerra Fria. O único uso documentado de armas biológicas em combate foi pelos japoneses contra cidades chinesas no final da década de 30 e início da década de 40. Também foram atribuídos aos japoneses experimentos com agentes bacteriológicos em "cobaias" humanas (principalmente prisioneiros de guerra).
Esses microorganismos são transformados em armas letais em laboratórios de vários países. Na lista de produtores de armas biológicas estão Iraque, Irã, Síria, Líbia, Índia, Paquistão e China. Além disso, o serviço de inteligência americano informou que países como Estados Unidos, Rússia, Irã, Iraque, Líbia, Coréia do Norte e Afeganistão mantêm esses laboratórios, onde cultivam as chamadas armas de destruição de massa.
Documento da Organização Mundial da Saúde, divulgado recentemente, alerta ser real a ameaça do uso de armas biológicas. Os especialistas da OMS constatam que "avanços em tecnologia tornaram possível aos terroristas matarem milhões de pessoas com armas biológicas e químicas". Eles relatam, em 179 páginas, todos os conhecimentos disponíveis sobre o bioterrorismo. A OMS recebeu vários telefonemas de governos solicitando conselhos de como combater uma possível guerra biológica.
Anthrax, botulismo, varíola e vírus Ebola integram o arsenal do terrorismo biológico. Como o antraz, o botulismo e diversas pestes estão presentes na maioria dos continentes, suas toxinas são facilmente obtidas. Baratos de produzir e simples de transportar podem atingir com pequena quantidade área muito grande.
As mais temidas armas biológicas
Varíola
 A varíola é adquirida através de um vírus, transmitido pelo ar, por isso a contaminação ocorre através da respiração.
A varíola é adquirida através de um vírus, transmitido pelo ar, por isso a contaminação ocorre através da respiração.Essa doença, como as outras usadas como armas, apresenta sintomas semelhantes aos da gripe. A erupção de pústulas na pele é uma das características da doença.
Os últimos casos confirmados de varíola foram diagnosticados há mais de duas décadas. existem, no mundo, dois laboratórios conhecidos com estoque de vírus vivo: um nos estados unidos e o outro na Rússia. após exposição respiratória e um período de incubação de 12 dias, a varíola evolui, em pacientes não vacinados, com taxas de mortalidade em torno de 30%.
Dois antivirais disponíveis comercialmente têm atividade contra o vírus da varíola: o cidofovir e a ribavirina. não se dispõe, atualmente, de vacina comercialmente disponível; o centers for disease control (cdc) tem uma reserva de alguns milhões de doses da vacina para prevenir uma nova emergência da doença e outro tanto de imunoglobulina para tratar os potenciais complicações da vacina.
Ebola
 O Ebola é um dos agentes de guerra biológica mais temíveis. A mortalidade atinge quase 100%. Após a contaminação, a pessoa passa a sentir, em uma semana, febre, muita dor de cabeça, falta de ar, a ter diarréia com sangue e expectoração também hemorrágica. A vítima morre, no máximo, em duas semanas. Não há tratamento para essa doença contagiosa, transmitida de pessoa a pessoa pela respiração, catarro, secreção ou , gotículas de tosse. Para uma pessoa ser contaminada bastam apenas 10 vírus. A disseminação pode ser por aerossol ou ,ainda, por alimento ou água contaminados pelo vírus. Classificado como um vírus de fácil cultivo e armazenamento , o Ebola pode ficar vários anos em um tubo de ensaio até ser espalhado na população. O Ebola é uma arma letal.
O Ebola é um dos agentes de guerra biológica mais temíveis. A mortalidade atinge quase 100%. Após a contaminação, a pessoa passa a sentir, em uma semana, febre, muita dor de cabeça, falta de ar, a ter diarréia com sangue e expectoração também hemorrágica. A vítima morre, no máximo, em duas semanas. Não há tratamento para essa doença contagiosa, transmitida de pessoa a pessoa pela respiração, catarro, secreção ou , gotículas de tosse. Para uma pessoa ser contaminada bastam apenas 10 vírus. A disseminação pode ser por aerossol ou ,ainda, por alimento ou água contaminados pelo vírus. Classificado como um vírus de fácil cultivo e armazenamento , o Ebola pode ficar vários anos em um tubo de ensaio até ser espalhado na população. O Ebola é uma arma letal.Peste bubônica
A peste bubônica usada como arma biológica é uma das formas mais temíveis por causa da alta infecciosidade, transmissibilidade e mortalidade. Uma vez disseminada, pode perdurar por muitos meses na água e no solo, continuando sua transmissibilidade.A peste bubônica pode ser disseminada por aerossóis, mísseis, bombas ou através de pulga infectada. 50 quilos de esporos dessa bactéria podem contaminar uma cidade de 5 milhões de habitantes. Uma vez infectada, a pessoa vai contagiar todas as outras com que tiver contato.
Os sintomas aparecem em três dias. A doença atinge o ápice em uma semana, período em que a pessoa pode morrer. Começa com um quadro parecido com gripe, depois aparecem pústulas e gânglios generalizado no corpo e úlcera na pele. É altamente contagiosa.
O tratamento é com antibióticos. E conta que é justamente nas regiões do Oriente Médio, África e sudeste asiático que a bactéria causadora da peste bubônica é cultivada com extrema facilidade. Então, com certeza, são muitos os países que têm esse agente infeccioso, que pode, ainda ser disseminado por animais domésticos, como o cão, o gato, gado e porcos.
Anthrax
Uma das armas biológicas mais temidas chama-se ANTHRAX, uma bactéria que dá o nome a uma doença desconhecida pela maioria dos médicos. Ao ser lançado por avião, o anthrax contamina o ar, a água, o solo e os alimentos. É tão pequeno que centenas de milhares desse bacilo cabem num único tubo de ensaio.Se forem espalhados por aeronave ao longo de dois quilômetros podem se estender, com a ajuda do vento, por 20 quilômetros, enquanto está sendo espalhado não pode ser detectado porque é incolor e sem cheiro.As pesquisas da universidade americana relatam que documentos de 1995 indicam que o Iraque produziu até 8 mil litros de anthrax para serem lançados por mísseis Scud. Mesmo com a pressão internacional, a produção de armas biológicas do Iraque continua intacta.
O anthrax pode lesar a pele, contaminar os pulmões ou causar doenças gastrintestinais. Começa como se fosse uma gripe. A pessoa passa a sentir dor no corpo, a expelir catarro. Depois, passa a ter manchas e pequenas vesículas na pele. Evolui, em seguida para hemorragia, edema e falência dos órgãos. A pessoa pode morrer em cinco dias. A bactéria anthrax pode, ainda, causar meningite, que significa morte.
Para se prevenir é necessário cobrir todo o corpo com roupas com duas camadas e equipamento de proteção respiratória. Para as roupas pode ser qualquer tecido. O importante é que proteja todo o corpo, porque o bacilo não penetra nos poros do tecido.
Tratar o anthrax significa usar antibióticos, "penicilina e tetraciclina". O contágio de pessoa para pessoa não é conhecido.
Toxina botulínica
A toxina botulínica é como agente numa guerra biológica. Essa toxina é considerada como a mais potente toxina conhecida pelo homem. É 10 mil a 100 mil vezes mais potente que qualquer outra.Ela provoca sintomas de paralisia progressiva, principalmente paralisia dos músculos da respiração, levando á falta de ar. Não tem tratamento. A mortalidade é alta.
Numa guerra biológica, é espalhada sobre reservatórios de água ou estoques de alimentos. Com spray, pode contaminar alimentos prontos. O consumo dessa água ou desses alimentos leva à imediata intoxicação. Depois de contaminados, não há como purificar essa água ou esses alimentos. Nem com o calor, caso os alimentos sejam cozidos ou assados. A evolução da doença acontece de 12 a 36 horas após a ingestão desses produtos. A morte pode ocorrer em 48 horas.
Toxina t-2
A toxina t-2 é usada em guerra biológica porque em minutos provoca irritação na garganta, diarréia e dores abdominais, que podem se prolongar por uma semana. Provoca alterações cardíacas, tontura e convulsões. Não tem tratamento e causa a morte por hemorragia. É uma toxina que fica no ar, provocando intoxicações e intoxicações por longo tempo.Essa toxina deriva de fungos e é cultivada em vários alimentos como o milho e o trigo. É capaz de destruir tecidos, principalmente os que apresentam multiplicação como a medula óssea, por exemplo. Podem causar destruição também no sistema gastrintestinal, no testículo e vários outros sistemas.
Os sintomas da contaminação pela toxina t-2 são imediatos. Ocorrem em poucos minutos, após a exposição, e podem durar até dez dias. Para produzi-la não é necessária tecnologia complicada, são apenas técnicas de extração e purificação. Ela ocorre com certa facilidade em ambientes de estocagem de grãos. É, portanto, um veneno fácil de produzir. Como não é destruída pelo calor, pode ficar estocada por muito tempo. Não se sabe quais países estariam usando, mas é de se imaginar que todos os que eventualmente estão pensando em armas biológicas, devem ter estoques destas substâncias tóxicas e de outras também. Só esperam pela oportunidade de disseminá-las. Ela pode ser espalhada por aerossóis. À medida em que vai descendo, vai atingindo as pessoas na pele, pela respiração ou pelos alimentos.
A toxina t-2 é mais uma arma biológica que não pode ser detectada por nenhum sistema de segurança por não ter nem cor nem cheiro, seus sintomas também são como os da gripe.
O bioterrorismo
Os americanos buscam auxílio lotando consultórios de psicólogos e esgotando estoques de máscaras e antibióticos para se proteger de um inimigo invisível: o bioterrorismo. O que o país mais desenvolvido sabe sobre o tratamento das doenças causadas por esses vírus ou bactérias? A resposta surpreende: muito pouco, admitem os cientistas americanos. Hoje, nomes como anthrax, botulismo, toxina t-2 ou varíola causam pânico entre os americanos. E comemoração entre os terroristas. É a grande arma do terrorismo. A mais temida no mundo, definem médicos e cientistas das principais universidades americanas.
Os americanos buscam auxílio lotando consultórios de psicólogos e esgotando estoques de máscaras e antibióticos para se proteger de um inimigo invisível: o bioterrorismo. O que o país mais desenvolvido sabe sobre o tratamento das doenças causadas por esses vírus ou bactérias? A resposta surpreende: muito pouco, admitem os cientistas americanos. Hoje, nomes como anthrax, botulismo, toxina t-2 ou varíola causam pânico entre os americanos. E comemoração entre os terroristas. É a grande arma do terrorismo. A mais temida no mundo, definem médicos e cientistas das principais universidades americanas.O alerta sobre o uso de armas biológicas foi feito durante reunião dos países da OTAN - Organização do Tratado do Atlântico Norte, em Bruxelas: "Temos de começar a pensar o impensável", declarou o secretário geral da OTAN, George Robertson, sobre o uso de armas biológicas por terroristas.
Uma arma invisível, sem cheiro e que provoca sintomas desconhecidos pela maioria dos médicos é a grande preocupação do governo norte-americano tanto nos ataques terroristas aos EUA como durante uma guerra no Afeganistão. É a arma biológica, que o Centro para Estudos de Biodefesa Civil da Universidade Johns Hopkins, nos Estados Unidos, define como a mais temida numa guerra. Estudos da Universidade Johns Hopkins mostram que os Estados Unidos "não estão preparados para enfrentar um ataque de arma biológica".
Todas as armas biológicas têm uma mesma característica. O maior medo é que os sintomas iniciais são bem semelhantes à gripe, com irritação da garganta, tosse e catarro, depois é que aparecem as lesões fatais. A maioria não tem tratamento. O Centro de Controle de Doenças dos Estados Unidos enviou um comunicado a todos os laboratórios americanos para avisarem em casos de surtos de gripe.
Exemplos da quantidade de vírus ou bactérias necessários para infectar uma população: dois quilos de anthrax, varíola ou t-2 podem contaminar uma população de 150 mil a 300 mil pessoas. Se forem 5 milhões pessoas, são suficientes pouco mais de 30 quilos do vírus da varíola.
O medo da utilização de armas biológicas causou mais prejuízos aos EUA. O governo proibiu todos os vôos de aviões utilizados para pulverizar plantações. A causa foi o medo de terroristas usarem essas aeronaves para espalhar vírus ou bactérias letais em várias regiões americanas.
O uso de vírus e bactérias para infectar soldados ou dizimar populações vem se tornando o pesadelo dos americanos. O risco do bioterrorismo vem sendo alertado pela Organização Mundial da Saúde, após os atentados a Nova York e a Washington. O Centro de Controle de Doenças dos Estados Unidos mandou uma determinação a todos os laboratórios para a comunicação imediata de sintomas das doenças que podem ser causadas por essas armas biológicas. É o bioterrorismo, uma técnica que espalha doenças ainda desconhecidas pela maioria dos médicos, ao transformar geneticamente vírus e bactérias em agentes resistentes a qualquer tratamento.
O método é antigo, mas continua um enigma para quem desenvolve diagnósticos e tratamentos.
São vários os vírus e as bactérias que podem ser desenvolvidas em laboratório para serem, depois, espalhadas por aviões ou lançadas por mísseis durante ataques terroristas ou durante uma guerra. Num simples tubo de ensaio cabem milhões desses micróbios, que podem, por exemplo, serem jogados num sistema de ventilação de um prédio, contaminando todos os moradores.
Conclusão
Realmente as armas biológicas representam um perigo real e assustador, capaz de exterminar um grande número de pessoas, elas vêm aterrorizando o mundo.Considerando-se a rapidez com que se adquire tecnologia de ponta em todas as áreas da ciência, é perfeitamente possível imaginar que um laboratório, trabalhando com estes (ou outros) microrganismos, possa primeiramente torná-los disponíveis em quantidades capazes de afetar o mundo inteiro e em seguida transformá-los (por manipulações genéticas) em agentes resistentes a todos os mecanismos de defesa atualmente existentes, tais como antimicrobianos, antivirais, vacinas, imunoglobulinas e outros mais.
Só nos resta então a dúvida: o homem é capaz de criar em laboratório microorganismos causadores de doenças fatais, mas não é capaz de encontrar a cura desses males?...Será que ele não será vítima de suas próprias invenções?...
Nenhum comentário:
Postar um comentário